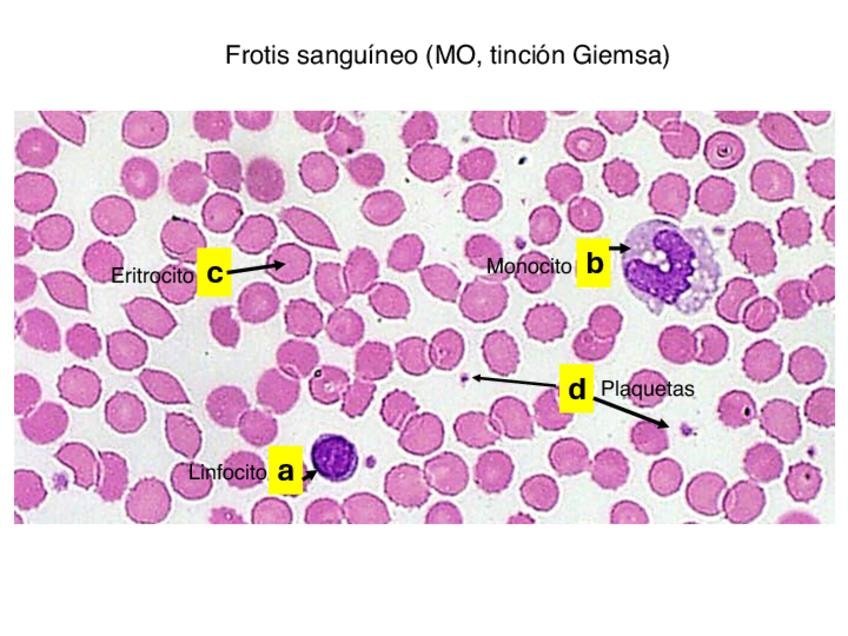

Histología Humana
He publicado nuevos apuntes de 1º Histología Humana: RECOPILATORIO-EXAMENES.pdf
He publicado nuevos apuntes de 1º Histología Humana: SEMINARIOS-PARCIAL-2.pdf
He publicado nuevos apuntes de 1º Histología Humana: TUBO-DIGESTIVO-.-Esofago-y-Estomago.pdf
He publicado nuevos apuntes de 1º Histología Humana: Aparato-Reproductor-Masculino.pdf
He publicado nuevos apuntes de 1º Histología Humana: VIAS-URINARIAS-2.pdf
He publicado nuevos apuntes de 1º Histología Humana: GLANDULAS-ANEXAS-AL-TUBO-DIGESTIVO-1.pdf
He publicado nuevos apuntes de 1º Histología Humana: SISTEMA-NERVIOSO-1.pdf
He publicado nuevos apuntes de 1º Histología Humana: APARATO-CIRCULATORIO-1-1.pdf
He publicado nuevos apuntes de 1º Histología Humana: Aparato-Reproductor-Femenino-Completo-2.pdf
He publicado nuevos apuntes de 1º Histología Humana: SEMILARIO-X-RESUELTO.pdf
He publicado nuevos practicas de 1º Histología Humana: Practica-histologia-4-mayo-endocrino-y-respiratorio.pdf
He publicado nuevos practicas de 1º Histología Humana: Urinario-y-reproductor.pdf
He publicado nuevos apuntes de 1º Histología Humana: Tabla-resumen-timo-ganglio-y-bazo-B8-Sist.-Inmunitario.pdf
He publicado nuevos apuntes de 1º Histología Humana: TEMA-28-SISTEMA-ENDOCRINO.pdf
He publicado nuevos apuntes de 1º Histología Humana: TEMA-41-VIAS-RESPIRATORIAS.pdf
He publicado nuevos apuntes de 1º Histología Humana: TEMA-42-PULMONES.pdf
He publicado nuevos apuntes de 1º Histología Humana: SEMINARIO-IX-RESUELTO.pdf
He publicado nuevos apuntes de 1º Histología Humana: SEMINARIO-VIII-RESUELTO.pdf
He publicado nuevos apuntes de 1º Histología Humana: SEMINARIO-VIII-RESUELTO.pdf
He publicado nuevos apuntes de 1º Histología Humana: SEMINARIO-VII-RESUELTO.pdf
He publicado nuevos apuntes de 1º Histología Humana: SEMINARIO-VI-RESUELTO.pdf
He publicado nuevos apuntes de 1º Histología Humana: IMPORTANTE-EXAMEN-HISTO.pdf
He publicado nuevos apuntes de 1º Histología Humana: Tabla-arteriolas-capilares-y-venulas.pdf
He publicado nuevos apuntes de 1º Histología Humana: SEMINARIO-V-RESUELTO.pdf
He publicado nuevos apuntes de 1º Histología Humana: Tabla-variedad-muscular-T14-B5.pdf
He publicado nuevos apuntes de 1º Histología Humana: Ganglios-linfaticos.-Tema-26.pdf
He publicado nuevos apuntes de 1º Histología Humana: Introduccion-al-sistema-inmunitario-el-timo.-Tema-25.pdf
He publicado nuevos apuntes de 1º Histología Humana: Sistema-vascular-histologia.-Temas-21-24.pdf
He publicado nuevos apuntes de 1º Histología Humana: Histologia-Seminario-3-tejido-sanguineo-y-muscular.pdf
He publicado nuevos apuntes de 1º Histología Humana: Histologia-Seminario-2-T.-Adiposo-Cartilago-y-Hueso.pdf
He publicado nuevos apuntes de 1º Histología Humana: SEMINARIO-IV-RESUELTO-GRUPO-A.pdf
He publicado nuevos apuntes de 1º Histología Humana: Tejido-nervioso-histologia.pdf
He publicado nuevos apuntes de 1º Histología Humana: Tejido muscular histología. Temas 14,15,16.pdf
practicas
-
Seminarios
He publicado nuevos practicas de 1º Histología Humana: Seminarios
He publicado nuevos apuntes de 1º Histología Humana: SEMILARIO-III-RESUELTO.pdf
He publicado nuevos apuntes de 1º Histología Humana: Resumentabla-t27-HISTOLOGIA.pdf
He publicado nuevos apuntes de 1º Histología Humana: Resumentabla-T26.pdf
He publicado nuevos apuntes de 1º Histología Humana: Resumentabla-T25-HISTOLOGIA.pdf
SEMINARIOS TEJIDO NERVIOSO
He publicado nuevos apuntes de 1º Histología Humana: ESQUEMA-BLOQUEesquema-NERVIOSO-HISTO.pdf
He publicado nuevos apuntes de 1º Histología Humana: Esquematabla-BLOQUE-VASCULAR-HISTO.pdf
He publicado nuevos apuntes de 1º Histología Humana: Esquematabla-bloque-muscular.pdf
He publicado nuevos apuntes de 1º Histología Humana: Esquematabla-T13-histo.pdf
He publicado nuevos apuntes de 1º Histología Humana: Esquematabla-T11-12-histologia.pdf
He publicado nuevos apuntes de 1º Histología Humana: Esquematabla-T9-10-histo.pdf
He publicado nuevos apuntes de 1º Histología Humana: SEMINARIO-II-RESUELTO.pdf
He publicado nuevos apuntes de 1º Histología Humana: esquematabla-t8-histo.pdf
He publicado nuevos apuntes de 1º Histología Humana: Esquematabla-t7-histo.pdf
He publicado nuevos apuntes de 1º Histología Humana: Esquematabla-T6-histo.pdf
He publicado nuevos apuntes de 1º Histología Humana: Esquematabla-T5-histo.pdf
Esquemas de la primera parte de la asignatura, que entra en el primer parcial.